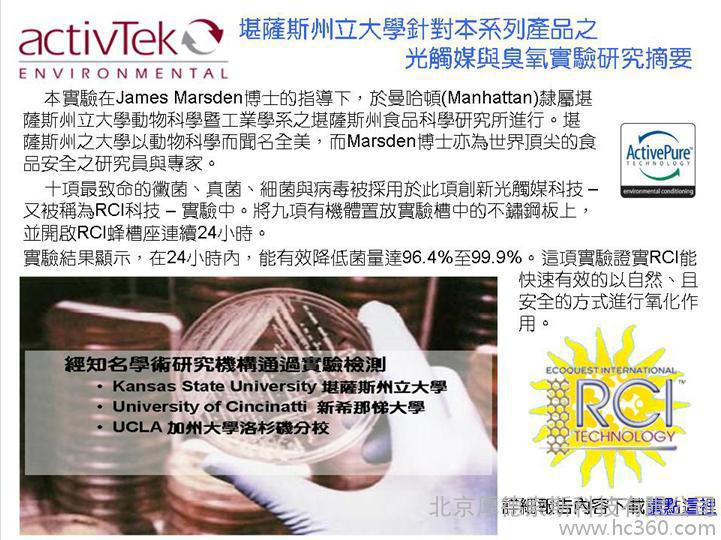

| 适用面积 | 186平方米 |
|---|---|
| 外形尺寸(mm) | 245*245*295 |
| 品牌 | Activtek |
| 型号 | INDUNCT2000空气净化器 |
本公司供应INDUNCT2000空气净化器,品牌Activtek,型号 INDUNCT2000空气净化器。参数为:适用面积* 23--279平方米,外形尺寸(mm)* 245*245*295。质量保证,欢迎咨询洽谈。
INDUNCT2000空气净化器,风机盘管配套空气净化器,安装在风机盘管机组内或送风风道上。它结构紧凑,体积小,重量轻,无需清洗。
采用了美国太空总署NASA所运用与太空舱内净化空气的ActivePure先进技术,大大减少了异味、可见烟雾和常见于在空气和表面的有害细菌病毒微生物,应用于住宅家中、办公室以及各种公共场所等室内环境。
Activtek空气净化器利用ActivePure科技,ActivTek INDUCT500得以大量消灭常见室内污染物比如可见烟尘,异味和空气中以及物体表面的微生物。
ActivePure由一种特殊的紫外光和光催化剂组成,它们进行一系列的**氧化过程并释放出数种有益的氧化剂。
随着人们生活水平的提高,家庭住宅和别墅都会精装修,各种建筑材料、家具、地毯、胶水和油漆等造成房间内开始了充满污染物如甲醛、苯和装修异味。严重危害着您和家人得健康。特别是有老人、儿童、孕妇的家庭。
科学实验表明,
ActivTek空气净化器可以大量消灭物体表面的微生物,包括但不限于大肠杆菌,单核细胞增多性李司忒氏菌,链球菌,绿脓杆菌,杆菌,金黄色酿脓葡萄球菌,白色念珠菌和纸葡萄穗霉菌。该产品并非医疗器械,不能诊断,治疗和治愈任何疾病。
专业品质,值得您信赖!赶紧联系我们订购吧!
北京厚德索斯科技有限公司诚邀各级代理商!








 生成海报
生成海报










